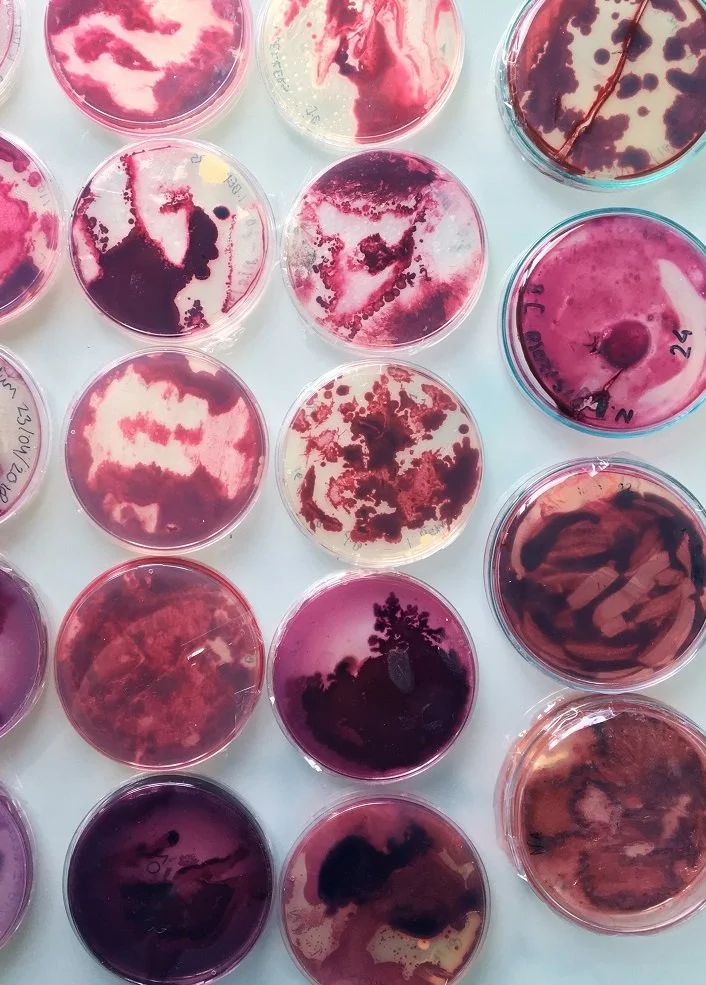
Multiple petri dishes with various shades of red, pink, and purple bacterial or fungal cultures growing inside.

Community biology refers to the practice of involving local communities, citizens, and non-professional individuals in scientific research, data collection, and other biological/science related activities. This approach aims to democratize science, increase public understanding of scientific concepts, and contribute valuable data to scientific research.
As the previous chairperson of Biologigargen, a non-profit community science research lab, I take pride in guiding residents to actively engage in scientific exploration and cultivate a profound connection to the environment. Through collaborative efforts, we contribute to both scientific advancement and a more scientifically literate and environmentally conscious community.
I was honored to be an MIT Global Bio fellow in 2019, where I had the opportunity to collaborate with fellow innovators and thought leaders in the field of biotechnology, open-source science, and community laboratories.
Exploring groundbreaking ideas and pushing the boundaries of bio innovation. My passion for biomaterial research fuels my drive to create sustainable and innovative solutions, leveraging biological systems to develop cutting-edge materials with applications ranging from medicine to environmental sustainability.
Working in this field has led me across the world with my project-based biomaterial research as well as teaching in multiple universities as a guest lecturer as well as helping develop the following skills.
• Basic lab skills } Usage of machines such as autoclaves, PCR machines, and MDS management via ERA software. Solution handling skills, building instrumentation, weighing, glassware management, and basic lab dailies to ensure the lab was BSL1 compliant.
• Communicating science outside of an academic view } contributing to Horizon 2020 research, MIT hiveminds, citizen science conferences, poster presentations, curating talks at scientific conferences, and guest speaking at events such as AfterIGEM.
• Innovation within Biotechnology/Biomaterials } Creating bioplastics from food waste, learning and educating about fermentation, lactic acids, and naturally occurring polymers/monomers. Creating growth media and cultivating micro-organisms (BSL1) for use within the textile industry.